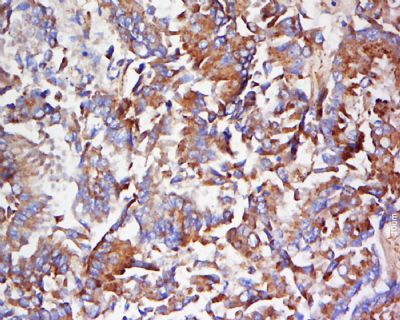
产品细节图片2

相关产品推荐更多 >
万千商家帮你免费找货
0 人在求购买到急需产品
- 详细信息
- 文献和实验
- 技术资料
- 供应商:
上海联迈生物工程有限公司
- 库存:
大量
- 目录编号:
LM-6175R
- 克隆性:
多克隆
- 抗原来源:
Rabbit
- 保质期:
1年
- 抗体英文名:
RAB5
- 抗体名:
ras癌基因家族Rab5蛋白抗体
- 宿主:
Rabbit
- 适应物种:
Human, Mouse, Rat, Chicken, Dog, Cow, Horse, Rabbit,
- 免疫原:
KLH conjugated synthetic peptide derived from human RAB5.:8-100/215
- 亚型:
IgG
- 形态:
Lyophilized or Liquid
- 应用范围:
WB=1:500-2000 ELISA=1:500-1000 IHC-P=1:400-800 IHC-F=1:400-800 IF=1:100-500 (石蜡切片需做抗原修复)
- 浓度:
1mg/ml
- 保存条件:
Store at -20 °C
- 规格:
50ul 100ul 200ul
| 英文名称 | RAB5 |
| 中文名称 | ras癌基因家族Rab5蛋白抗体 |
| 别 名 | RAB 5; RAB 5A; RAB5A; RAB5A member RAS oncogene family; RAB5A_HUMAN; RAS associated protein RAB5A; Ras related protein Rab 5A; Ras-related protein Rab-5A. |
| 规格价格 | 50ul/780元 购买 100ul/1380元 购买 200ul/2200元 购买 大包装/询价 |
| 说 明 书 | 50ul 100ul 200ul |
| 研究领域 | 细胞生物 神经生物学 信号转导 转运蛋白 |
| 抗体来源 | Rabbit |
| 克隆类型 | Polyclonal |
| 交叉反应 | Human, Mouse, Rat, Chicken, Dog, Cow, Horse, Rabbit, |
| 产品应用 | WB=1:500-2000 ELISA=1:500-1000 IHC-P=1:400-800 IHC-F=1:400-800 IF=1:100-500 (石蜡切片需做抗原修复) not yet tested in other applications. optimal dilutions/concentrations should be determined by the end user. |
| 分 子 量 | 24kDa |
| 细胞定位 | 细胞浆 细胞膜 |
| 性 状 | Lyophilized or Liquid |
| 浓 度 | 1mg/ml |
| 免 疫 原 | KLH conjugated synthetic peptide derived from human RAB5.:8-100/215 |
| 亚 型 | IgG |
| 纯化方法 | affinity purified by Protein A |
| 储 存 液 | 0.01M TBS(pH7.4) with 1% BSA, 0.03% Proclin300 and 50% Glycerol. |
| 保存条件 | Store at -20 °C for one year. Avoid repeated freeze/thaw cycles. The lyophilized antibody is stable at room temperature for at least one month and for greater than a year when kept at -20°C. When reconstituted in sterile pH 7.4 0.01M PBS or diluent of antibody the antibody is stable for at least two weeks at 2-4 °C. |
| PubMed | PubMed |
| 产品介绍 | background: Rab5-related subfamily. This subfamily includes Rab5 and Rab22 of mammals, Ypt51/Ypt52/Ypt53 of yeast, and RabF of plants. The members of this subfamily are involved in endocytosis and endocytic-sorting pathways. In mammals, Rab5 GTPases localize to early endosomes and regulate fusion of clathrin-coated vesicles to early endosomes and fusion between early endosomes. In yeast, Ypt51p family members similarly regulate membrane trafficking through prevacuolar compartments. GTPase activating proteins (GAPs) interact with GTP-bound Rab and accelerate the hydrolysis of GTP to GDP. Guanine nucleotide exchange factors (GEFs) interact with GDP-bound Rabs to promote the formation of the GTP-bound state. Rabs are further regulated by guanine nucleotide dissociation inhibitors (GDIs), which facilitate Rab recycling by masking C-terminal lipid binding and promoting cytosolic localization. Most Rab GTPases contain a lipid modification site at the C-terminus, with sequence motifs CC, CXC, or CCX. Lipid binding is essential for membrane attachment, a key feature of most Rab proteins. Due to the presence of truncated sequences in this CD, the lipid modification site is not available for annotation. Subunit: Binds EEA1. Interacts with RIN1 and GAPVD1, which regulate its pathway, probably by acting as a GEF. Interacts with ALS2CL, RABEP1, SUN2, ZFYVE20 and RUFY1. Interacts with SGSM1 and SGSM3. Interacts with PIK3CB. Subcellular Location: Cell membrane; Lipid-anchor; Cytoplasmic side. Early endosome membrane; Lipid-anchor. Melanosome. Similarity: Belongs to the small GTPase superfamily. Rab family. SWISS: P20339 Gene ID: 5868 Database links: Entrez Gene: 5868 Human Entrez Gene: 271457 Mouse Entrez Gene: 64633 Rat Omim: 179512 Human SwissProt: P20339 Human SwissProt: Q9CQD1 Mouse Unigene: 475663 Human Unigene: 329123 Mouse Unigene: 44477 Rat Important Note: This product as supplied is intended for research use only, not for use in human, therapeutic or diagnostic applications. |
| 产品图片 | ![]() Sample: Brain (Mouse) Lysate at 40 ug Primary: Anti-RAB5 (bs- 6175R) at 1/300 dilution Secondary: IRDye800CW Goat Anti-Rabbit IgG at 1/20000 dilution Predicted band size: 24 kD Observed band size: 26 kD ![]() Tissue/cell: human lung carcinoma; 4% Paraformaldehyde-fixed and paraffin-embedded; Antigen retrieval: citrate buffer ( 0.01M, pH 6.0 ), Boiling bathing for 15min; Block endogenous peroxidase by 3% Hydrogen peroxide for 30min; Blocking buffer (normal goat serum,C-0005) at 37℃ for 20 min; Incubation: Anti-RAB5 Polyclonal Antibody, Unconjugated(bs-6175R) 1:500, overnight at 4°C, followed by conjugation to the secondary antibody(SP-0023) and DAB(C-0010) staining |
风险提示:丁香通仅作为第三方平台,为商家信息发布提供平台空间。用户咨询产品时请注意保护个人信息及财产安全,合理判断,谨慎选购商品,商家和用户对交易行为负责。对于医疗器械类产品,请先查证核实企业经营资质和医疗器械产品注册证情况。
文献和实验PNAS:RAS 抑制剂又添一员,新型蛋白模拟物或为癌症治疗
13、RAB10、RAB14、RAB18、RAB5C 和 RAP1B)。序列分析表明,在 Sos 螺旋发夹结合区富集的 Ras 相关蛋白和其他 G 蛋白之间存在高度的序列相似性。图片来源:PNAS总的来说,该研究开发了一种 Sos 蛋白模拟物,它结合野生型和突变型 Ras,并对致癌 Ras 细胞具有选择性毒性作用。这种模拟物将为开发高 Ras 突变型癌症靶向抑制剂提供坚实的理论依据。延伸阅读该研究是同一团队十年前报道的跟进研究。图片来源:ScienceDirect 截图2011 年,Paramjit S
SopE-Mediated Recruitment of Host Rab5 on Phagosomes Inhibits Salmonella Transport to Lysosomes
Phagocytosis is a process by which invading organisms are taken up by macrophages and targeted to the lysosomes, where they are degraded. However, many pathogens modulate this central process of macrophage-mediated killing by inhibiting
-7表达水平降低(Takamizawa et al., 2004)。在动物体内,let-7的表达依赖于动物的生长发育周期,在发育早期let-7低表达,而分化成熟的组织let-7高表达。下调let-7的表达水平致使分化失败,从而导致了癌症的发生。另外,实验表明,RAS癌基因是miRNA let-7的直接靶点,说明在肺癌发生过程中,let-7通过调节RAS的表达发挥抑癌基因作用。第二种情况,通过作用于抗凋亡基因BCL2靶点,下调miR-15和miR-16在慢性淋巴瘤的表达。另一方面,致癌的miRNAs
技术资料暂无技术资料 索取技术资料